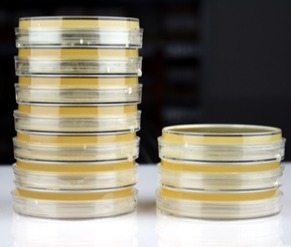
Mobirise

サンプル採集セット
サンプル採集セット 滅菌多目的容器(自立式)
滅菌多目的容器(自立式) 滅菌容器(ボトル)
滅菌容器(ボトル) ふき取り検査器材(スワブ法)
ふき取り検査器材(スワブ法) ふき取り検査器材(スタンプ法)
ふき取り検査器材(スタンプ法) 滅菌済みサンプリングバッグ
滅菌済みサンプリングバッグ 滅菌済みディスポスプーン
滅菌済みディスポスプーン 滅菌済みディスポピペット
滅菌済みディスポピペット微生物検査で使用される機器は培地の調製から検査、検体の廃棄に至る様々なものが使用されていますが、当サイトでは微生物検査に洗浄などの手間を省ける、検査の効率化が可能な滅菌済みディスポ製品を紹介しています。

~丈夫で耐熱性に優れています。~
培養後のシャーレなどをオートクレーブ滅菌する際に使用する袋です。
●特殊耐熱ポリプロピレン製
厚み:60μm
●口締めバンド付き
●中身が少し透けてみえる半透明

洗浄の必要がありません。
必要な時に必要な分だけすぐに使用できます。(急な試験依頼時に便利)
本体と蓋がプラスチック製の為、オートクレーブ後にまとめて廃棄可能。
①滅菌済希釈液の調製やサンプリング
②BGLB、LB、EC培地用にダーラム管入り試験管。
③理化試験用に滅菌無し製品も便利

培地へ検体を塗抹する為の、滅菌済みのコンラージ棒です。
滅菌済みディスポタイプの製品であるため、使用後の煩雑な洗浄・滅菌作業から開放されます。急に増加する検体を迅速に対応ができるので、人手不足や増員のコスト増にも回避されます。これによって職場では合理的な作業環境が実現します。

使用前後の洗浄・滅菌作業は不要です。製品ラインナップは通常容量の1ml、2ml、3mlがありますので、ご必要に応じてご注文してください。目安目盛りがあるので、操作の目安として便利に検液を採集できます。
※無滅菌、包装本数のご用命があればお好きな本数で包装致します。ぜひ一度お問い合わせ下さい。
※10ml(個包装)も販売しております。

画線塗抹及び釣菌作業に最適です。
滅菌済みの為、洗浄・滅菌の煩雑な作業からも開放されます。また、滅菌済みの為、コンタミネーションの心配がありません。
柔軟性のある素材の為、作業中に折れる心配がありません。
ループ部分は鏡面仕上げで培地表面を傷つけません。
持ち手部分は滑り止め加工済みです。

CBスタンプは、表面付着菌の拭き取り検査器具です。
高吸収力のスポンジを採用しました。
検査箇所を拭き取る場合は希釈水を含ませてもご使用いただけます。
操作が簡単なので、作業の標準化が図れます。
コンパクトに設計しており、持ち運びや保管場所を取らないです。
滅菌済みなので、事前の準備作業が便利にできます。

サンプリング用・保存食用に滅菌されたチャック式の袋です。
「原材料および調理済み食品を食品ごとに約50g程度ずつ清潔なポリエチレン袋(容器)に入れ密封し、-20℃以下で2週間以上保存する」にピッタリの検食保存用袋です。さらに、厚生労働省により規定されている原材料など購入した状態で保存する用にもお勧めします。
本製品はγ線滅菌された袋ですので検食やサンプリング作業などに殺菌・消毒の手間がいらず、迅速に検査対応が出来ます。

滅菌済みストマッカー用袋は三種類のサイズがあります。
①ストマッカー用袋(小)
②ストマッカー用袋(大)
③フィルター付ストマッカー用袋
フィルター付ストマッカー用袋をご利用される場合、サンプルを処理した後、検液採集側に切り口が付いているので、容易に開封できます。
チャック袋で保管できますので、必要な枚数だけお使いいただけます。
すべての材料がプラスチックなので、ゴミ分別せず廃棄出来ます。

滅菌済みですので、使用前の洗浄および滅菌作業が不要です。
先端部分に滑り止め加工があります。
1 本包装の使い捨てタイプですので、汚染のリスクを回避できます。長期保管にも適しています。
使い捨てタイプピンセットの使用例
●メンブランフィルターを取る際にご使用ください。
●検体の無菌採取にご使用ください。
1本包装のため、ピンセットを使用の度、必要な使用本数に応じて、お使いいただけます。

拭き取り検査後、軸の溝箇所を折ることで、採集綿棒部位の回収ができ、雑菌が入ることを防ぎます。
滅菌生理食塩水を合わせてご利用の場合は微生物の定量分析が適応します。
最低限の消耗品利用で検査コストを抑えます。
お客様は一度検査にご必要数が少量でも10本/袋の包装タイプなので、無駄なく便利です。
軸の部分15cmの長さで、複雑で入り込んだ機械装置の隙間なども適しています。

β-ラクタマーゼ(Beta-Lactamase)はβ-ラクタム環構造を加水分解する酵素の総称で、β-ラクタム環骨格を有する抗生物質の無菌試験や環境モニタリングなどに活用されています。しかし、近年のβ-ラクタム系抗生物質は構造が多岐に渡り、細菌由来β-ラクタマーゼに対する耐性を強められているため、従来の無菌試験用β-ラクタマーゼでは十分に分解することは難しく、分解困難な構造がありました。
Hangzhou Beiwang Biotechnology社が開発した複数の改変型β-ラクタマーゼの混合物で、従来のβ-ラクタマーゼよりも幅広いβ-ラクタム系化合物を分解することが可能です。
β-ラクタマーゼ酵素添加生培地は製薬業界の抗生物質生産企業のリスクを減らすために、β-ラクタマーゼ酵素濃縮生培地を開発しました。偽陰性のリスクによってもたらされた抗生物質の粉塵沈着の抗生物質生産ワークショップへの効果的なソリューションを提供しています。
定量法:
顧客はダストサンプルを提供することによって酵素添加量、種別を選定し、カスタマイズ製品を提供します。
定性法:
充填済みの酵素添加生培地を用いて顧客が検証を行い、効果的なものを採用します。
1-677-42 Higashi-Onari-cho, Kita-ku, Saitama-shi, Saitama, Japan
+81 (48) 610 8353
biosales@abcbio.net
Best AI Website Creator